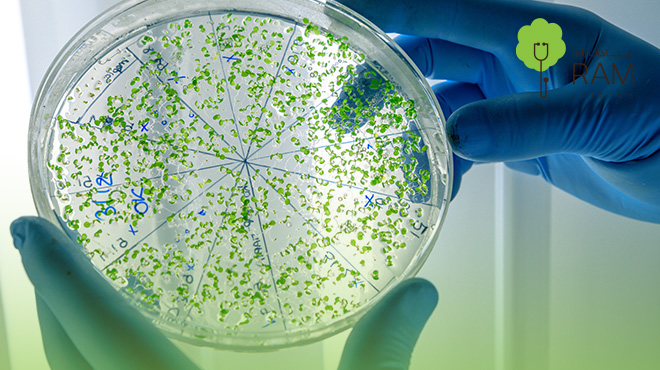
فوائد-البكتيريا-النافعة

تعتبر البكتيريا النافعة من العناصر المهمة والدقيقة التي تؤثر على صحة الجسم بشكل عام من الداخل إلى الخارج…
تعيش تلك الكائنات الصغيرة والبسيطة في الأمعاء لكن على الرغم من صغر حجمها إلا أنها تعزز من صحة المناعة بشكل عام ودعم الجهاز الهضمي.. لكن ما هي فوائد البكتيريا النافعة الأخرى؟
تابع قراءة المقال التالي لتتعرف على مزيد من التفاصيل…
محتوى المقال:
-
ما هي البكتيريا النافعة؟
-
فوائد البكتيريا النافعة للبشره
-
فوائد البكتيريا النافعة للمعدة
-
فوائد البكتيريا النافعة للقولون العصبي
-
فوائد البكتيريا النافعة للأطفال
-
مصادر البكتيريا النافعة
-
أعراض نقص البكتيريا النافعة
-
أهم النصائح لتعزيز البكتيريا النافعة:
-
تجربتي مع البكتيريا النافعة
فوائد البكتيريا النافعة:
على الرغم من أنها غير مرئية إلا أنها سر من أهم أسرار الحفاظ على صحة الجسم من الداخل إلى الخارج.
تلك الكائنات الدقيقة التي تعيش داخل الأمعاء في انسجام مذهل مع الجسم كما أنها تقوم بأدوار حيوية تتجاوز مجرد المساعدة في الهضم.
هناك العديد من فوائد البكتيريا النافعة التي تشمل دعم الجهاز المناعي، تحسين امتصاص الفيتامينات، المساهمة في توازن الوزن، وحتى التأثير على المزاج وصحة الجلد وفقًا لأبحاث حديثة.
لذلك الاهتمام بها أصبح جزء أساسي من أسلوب حياة صحي.
قبل أن نتعمق في فوائد البكتيريا النافعة… لنتعرف أولًا على ما هي البكتيريا النافعة وكيف تعيش داخل أمعائنا وماهي مصادرها..
ما هي البكتيريا النافعة؟
البكتيريا النافعة هي نوع من أنواع الكائنات الحية الدقيقة التي تعيش طبيعيًا داخل الجهاز الهضمي، تكون لها العديد من الفوائد على جسم الإنسان التي تتمثل في دعم عملية الهضم والمساعدة في امتصاص بعض الفيتامينات والعناصر الغذائية، والمساهمة في حماية الجسم من الميكروبات الممرضة عن طريق منافستها على الغذاء ومواقع الالتصاق في الأمعاء على عكس تمامًا البكتيريا الضارة.

تسمى البكتيريا النافعة أيضًا بـ البروبيوتيك طبيًا وهي أحد الركائز الأساسية لصحة الجهاز الهضمي والمناعة.
فوائد البكتيريا النافعة للبشرة:
هناك العديد من فوائد البكتيريا النافعة للبشرة حيث تلعب دورًا مهمًا في صحة البشرة وتحسين مظهرها، إليك أهم الفوائد:
-
تعزيز الحاجز الجلدي: تعمل البكتيريا النافعة للبشرة على تقوية حاجز الجلد مما يقلل من فقدان الرطوبة ويحمي البشرة من العوامل الخارجية الضارة.
-
تقليل الالتهابات: تعمل البكتيريا النافعة على تقليل الالتهابات التي تتمثل في حب الشباب والتهابات الجلد الخفيفة.
-
توازن الفلورا الجلدية: تعمل البكتيريا النافعة على توازن الميكروبيوم الموجود على الجلد مما يحمي الجلد من نمو البكتيريا الضارة.
-
تحسين نضارة البشرة: تدعم البكتيريا النافعة صحة الأمعاء مما تعمل على تحسين صحة البشرة وإشراقتها بشكل غير مباشر.
-
تخفيف مشاكل الجلد المرتبطة بالجهاز الهضمي: يمكن تحسين الإكزيما والتحسس الجلدي.
بالتالي يمكن الحفاظ على تحسين البشرة وتعزيز جمالها وصحتها بشكل ملموس من خلال البكتيريا النافعة.
فوائد البكتيريا النافعة للمعدة:
تلعب فوائد البكتيريا النافعة للمعدة في تحسين المعدة والجهاز الهضمي بشكل عام:

-
تحسين عملية الهضم: تعمل فوائد البكتيريا النافعة للمعدة على امتصاص العناصر الغذائية بشكل أفضل.
-
منع نمو البكتيريا الضارة: تحارب البكتيريا النافعة الالتهابات أو الاضطرابات الهضمية.
-
تقليل الانتفاخ والغازات: تساهم البكتيريا النافعة على تنظيم حركة الأمعاء كما يقلل من الامساك والانتفاخات.
-
دعم الجهاز المناعي المحلي: تعمل البكتيريا النافعة على تحسين جدار المعدة والأمعاء.
-
الوقاية من بعض اضطرابات المعدة: التي تتمثل في القولون العصبي والتهابات المعدة البسيطة.
ما هي فوائد البكتيريا النافعة للقولون العصبي؟
تلعب فوائد البكتيريا النافعة للقولون العصبي دورًا مهما في تحسين جودة الحياة لدى المرضى المصابين بمتلازمة القولون العصبي:
تقليل الانتفاخ والغازات: تنظيم حركة الأمعاء وتقليل الغازات التي يعاني منها مرضى القولون.
-
تخفيف الإسهال والإمساك: تعمل فوائد البكتيريا النافعة للقولون العصبي على تحقيق التوازن الطبيعي لحركة الأمعاء، مما يخفف من الإسهال والإمساك.
-
تحسين الراحة الهضمية: من خلال تحسين توازن الميكروبيوم تقل التقلصات وبالتالي تتحسن الراحة الهضمية.
-
تعزيز المناعة المعوية: من أهم فوائد البكتيريا النافعة للقولون العصبي أنها تعمل على دعم الدفاعات الطبيعية للقولون ضد البكتيريا الضارة.
-
تخفيف التهيج والالتهابات الخفيفة: تعمل فوائد البكتيريا النافعة للقولون العصبي على تقليل التهيج والالتهابات التي تعمل على تقليل التهيج الناتج عن اختلال توازن البكتيريا.
اختصارًا لما سبق فوائد البكتيريا النافعة للقولون العصبي تعمل على تحسين الأعراض الناتجة عن الانزعاج من متلازمة القولون.
ما هي فوائد البكتيريا النافعة للأطفال؟
هناك العديد من فوائد البكتيريا النافعة للأطفال التي تعمل على دعم النمو الصحي وتعزيز المناعة منذ مرحلة الطفولة المبكرة:
-
تعزيز مناعة الأطفال: حماية الأطفال من العدوى البكتيرية بسبب تقوية الجهاز المناعي.
-
دعم التوازن البكتيري: تحافظ البكتيريا النافعة على الميكروبيوم المعوي.
-
التأثير الإيجابي على المزاج والسلوك: تشير بعض الدراسات إلى أن توازن البكتيريا النافعة قد يؤثر على المزاج والقدرة على التركيز لدى الأطفال.
يمكن دعم البكتيريا النافعة للأطفال من خلال مصادر البكتيريا النافعة، إليك تلك المصادر فيما يأتي…
مصادر البكتيريا النافعة:
يمكن لـ مصادر البكتيريا النافعة الحفاظ على توازن الميكروبيوم المعوي ودعم صحة الجهاز الهضمي. إليك مصادر البكتيريا النافعة:
-
الأطعمة المخمرة:
تتمثل في الزبادي الطبيعي، الكفير، الملفوف المخمر، وهي غنية بالبكتيريا الحية المفيدة.
-
المخللات الطبيعية:
المصادر التي تحتوي على بروبيوتيك طبيعي يحافظ على صحة الأمعاء مثل: مخلل الخيار أو الشمندر.
-
الأطعمة المدعمة بالبروبيوتيك:
الحبوب والمكملات الغذائية التي توفر مصادر البكتيريا النافعة بشكل إضافي مثل الحبوب، العصائر، والمكملات الغذائية.
-
الألياف الغذائية:
تعمل الألياف الغذائية على مساعدة البكتيريا النافعة داخل الأمعاء وتعزيز نموها.
"باختصار" الالتزام بتناول مصادر البكتيريا النافعة تعمل على دعم المناعة وتحسين الهضم والوقاية من مشاكل الجهاز الهضمي.
ما هي أعراض نقص البكتيريا النافعة؟
يمكن أن تؤثر أعراض نقص البكتيريا النافعة على صحة الجهاز الهضمي والجسم بشكل عام، من أبرز أعراض نقص البكتيريا النافعة:

-
مشكلات هضمية متكررة: يعاني من الانتفاخ والغازات والإسهال المزمن.
-
ضعف امتصاص العناصر الغذائية: مما يؤدي إلى نقص الفيتامينات والمعادن الأساسية.
-
ضعف المناعة: تؤدي ضعف المناعة وضعف الدفاعات الطبيعية في الأمعاء إلى زيادة القابلية للعدوى.
-
مشكلات جلدية: ظهور حب الشباب أو الإكزيما بسبب عدم توازن الميكروبيوم.
-
تغيرات في المزاج: قد تشعر بتقلبات في المزاج وذلك من خلال القلق والتوتر.
لذا يجب الحفاظ على أعراض نقص البكتيريا النافعة للوقاية من الأعراض الضارة للقولون العصبي والحفاظ على الصحة العامة.
أهم النصائح لتعزيز البكتيريا النافعة:
للحفاظ على صحة الجهاز الهضمي والعصبي، يمكن اتباع النصائح التالية:
-
يجب تجنب الإفراط في تناول المضادات الحيوية: حيث تعمل كثرة المضادات الحيوية على تقليل البكتيريا النافعة.
-
ممارسة النشاط البدني: تساهم الرياضة المنتظمة في تحسين توازن الميكروبيوم المعوي.
-
الحد من السكريات والأطعمة المصنعة: الإفراط في تناول السكريات يعمل على تحفيز البكتيريا النافعة.
-
شرب كمية كافية من الماء: كثرة شرب الماء تعمل على تنظيم حركة الأمعاء.
اتباع تلك النصائح تساعد على تعزيز البكتيريا النافعة وتحسين المناعة بشكل عام.
تجربتي مع البكتيريا النافعة:
عند التركيز مع البكتيريا النافعة لاحظت فرق ملحوظ في صحتي الهضمية من خلال تجربتي مع البكتيريا النافعة شعرت بتحسن في حركة أمعائي: قل الإسهال والانتفاخ والغازات، كما اختفت مشاكل الإمساك التي أعاني منها.
لاحظت أن تجربتي مع البكتيريا النافعة انعكست على نشاطي اليومي فأصبحت أكثر نشاطًا وحيوية، أصبحت صحتي العامة أفضل بكثير.
على الرغم من بساطتها إلا أنها أحدثت فرق كبير!
لا يمكن إنكار الدور الحيوي لـ البكتيريا النافعة في تحسين جودة الحياة بشكل عام، لكن يبقى . الاهتمام بتعزيز هذه الكائنات الدقيقة من خلال التغذية السليمة، الأطعمة المخمرة، والألياف الغذائية، ليس خيارًا تجميليًا بل ضرورة صحية للحفاظ على التوازن الداخلي للجسم.
زيارة الطبيب في عيادات رام بالبحرين توفر لك تقييمًا دقيقًا لحالتك الصحية، توجيهًا متخصصًا حول كمية ونوع البروبيوتيك المناسب لك، ومتابعة مستمرة لضمان سلامتك وتحقيق أفضل النتائج.
احجزي الآن استشارتك لتلقي الرعاية الطبية الموثوقة!
قد ترغب في معرفة معلومات حول عمليات شد البطن في البحرين
أضف تعليقك